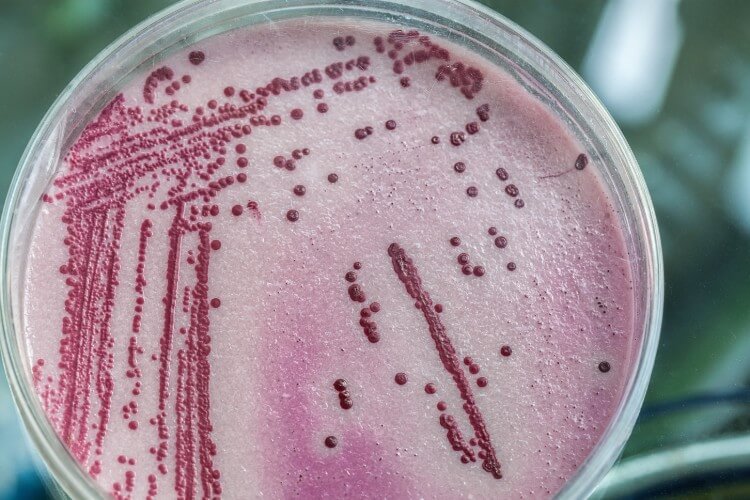
petri dish with bacteria growth

We are pleased to announce that Mawdsleys Pumps Services engineers have successfully undertaken training courses as part of our ongoing commitment to investment in water hygiene services.
The courses covered legionella risk assessment of commercial and cold water systems, legionella bacteria in hot and cold water systems, water hygiene and the 18th Edition Wiring Regulations.
Find out more about the qualifications and how they benefit our customers in our latest blog post.
City & Guilds WS8 – Legionella Risk Assessment of Commercial Hot and Cold Water Systems
This course relates to legionella risk assessments in commercial hot and cold water systems. In the trainer-led session, Mawdsleys engineers learned about topics including:
- The need for risk assessment
- Preparation and scope
- Determining risk
- Appraisal of management
- Appraisal of safe design / operation
- Appraisal of maintenance / monitoring / inspection
- System survey
The course is heavily focused on the highest standards of risk assessment and engineers who have completed this course will be able to undertake legionella risk assessments of larger hot and cold water systems.
City & Guilds WS2 – Management of Legionella Bacteria in Hot and Cold Water Systems
This course relates to the management of legionella bacteria in hot and cold water systems. Topics discussed throughout the training sessions included:
- Background
- Medical aspects
- Proliferation
- Definition
- Guidance available
- Smaller hot and cold water systems
- Gravity fed water systems
- Pressurised systems
- Compliance
- Flow throughput
- Thermal gain
- And much more.
Engineers who completed this course have greater knowledge of factors such as design, operation, management, and maintenance in relation to controlling legionella in hot and cold water systems.
National Water Hygiene Card
All of our water hygiene team have the EUSR (Energy & Utility Skills Register) National Water Hygiene card, otherwise known as a blue card. This is essential for engineers working with chlorination of cold water storage tanks or working with clean water.
As part of the course, learners are taught by an expert trainer on several topics including:
- The importance of water
- Water as a carrier of disease
- Potential contamination and its consequences
- Methods to prevent contamination
At the end of the session, Mawdsleys engineers were required to complete a written assessment to prove competence in their new learnings which all passed.

City & Guilds 18th Edition
Several of our engineers completed the City & Guilds Edition to understand the requirements of electrical installations in line with BS 7671:2018 18th Edition Regulations.
By law, any electrical installation that is being designed and installed must be done so in line with the latest IET Wiring Regulations including:
- Essential aspects of the safety
- Selection and erection of electrical equipment
- Inspection and testing
By completing the training, our engineers can ensure that any electrical work on pumping systems they complete is up to the standards of the latest regulations.
Having this knowledge as part of our in-house teams means we do not need to sub-contract, allowing us to offer more competitive pricing and fast turnaround.

Water Hygiene Services
As part of our continued investment in water hygiene, we can offer a range of specialist services to ensure your commercial or domestic water supply is in safe working order:
Talk to the Experts
At Mawdsleys Pumps, we hold a range of accreditations and certifications to provide complete peace of mind to our customers.
To find out more about the services we offer, including our water hygiene services give one of our team a call today on 0117 954 8030 or fill out a contact form and we will get back to you.
